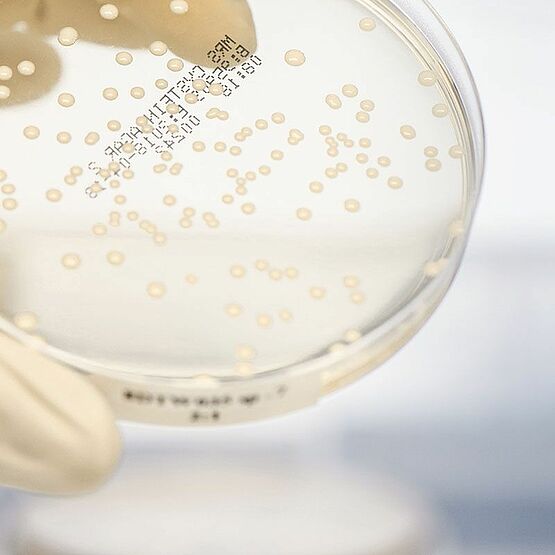
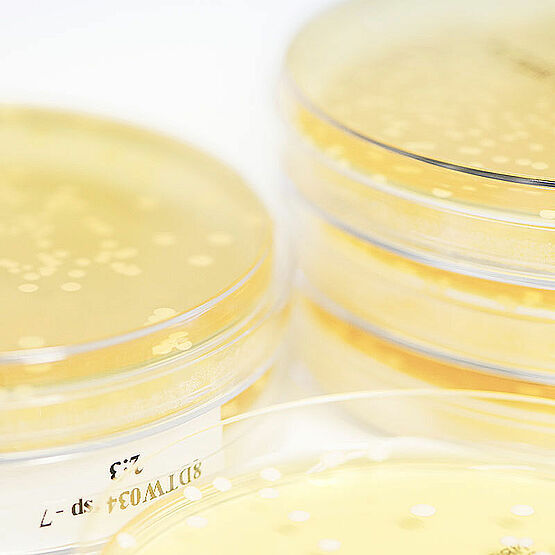

Cadouri de Crăciun pentru copii: idei creative și utile
Luna decembrie a sosit, aducând cu ea magia sărbătorilor, dar și agitația pregătirilor de Crăciun. Te întrebi constant ce cadouri să alegi pentru cei dragi, mai ales pentru copii? În același timp, vrei să eviți mormanele de jucării de acasă și să îi înveți să aprecieze cu adevărat lucrurile. BioGaia înțelege perfect această dilemă și are câteva idei inspirate pentru tine.